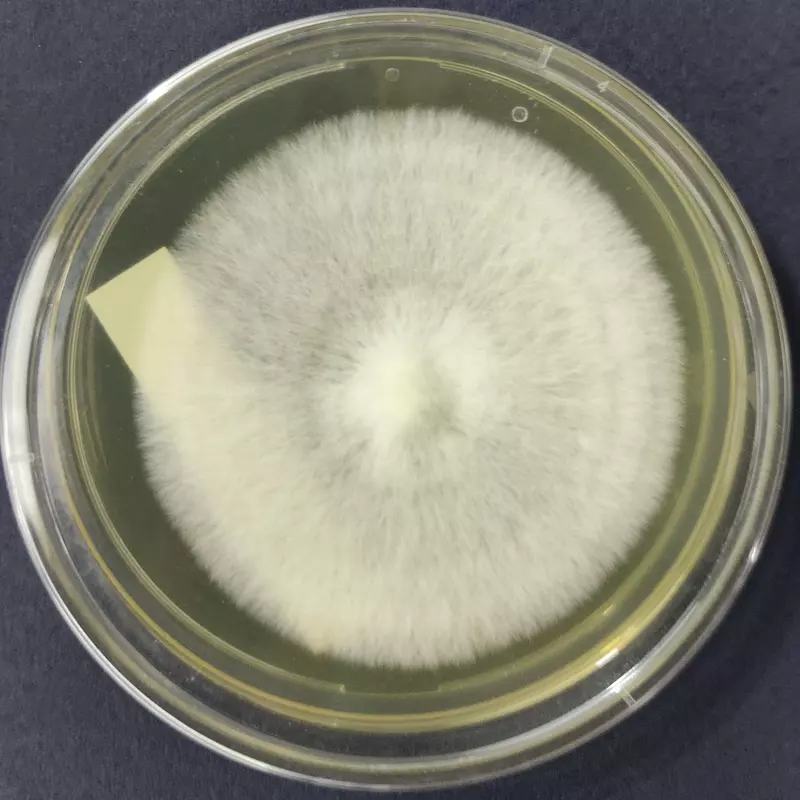

Cyclocybe aegerita (Poplar Mushroom) โ Pure Culture Plate
Premium Cyclocybe aegerita i.e. Agrocybe aegerita (Poplar / Pioppino Mushroom) pure culture plate for gourmet and specialty mushroom cultivation. Known for its rich earthy flavor, velvety brown caps, and vigorous growth, this verified strain is ideal for professional growers, research labs, and mycology enthusiasts.
๐ Proudly prepared and stored at Agripie Agrosystem LLP, India ๐ฎ๐ณ
The Cyclocybe aegerita i.e. Agrocybe aegerita (Poplar / Pioppino Mushroom) โ Pure Culture Plate offers a verified, contamination-free strain of one of Europeโs most traditional gourmet mushrooms.
Also called Pioppino or Black Poplar Mushroom, it is cherished for its firm texture, savory umami taste, and strong aroma that enhances a wide range of culinary dishes.
This culture demonstrates vigorous mycelial growth and consistent fruiting on hardwood substrates such as sawdust and logs. Perfect for commercial cultivation, spawn development, and strain research, it combines reliability, flavor quality, and aesthetic appeal.
Features:
Authentic Cyclocybe aegerita strain (Poplar / Pioppino Mushroom)
Fast-growing mycelium with excellent yield potential
Distinct nutty and earthy flavor for gourmet cuisine
Suitable for both indoor and outdoor cultivation setups
Ideal for commercial farms, laboratories, and advanced growers
100% pure, contamination-free culture plate
๐ Proudly prepared and stored at Agripie Agrosystem LLP, India ๐ฎ๐ณ

|
| 
